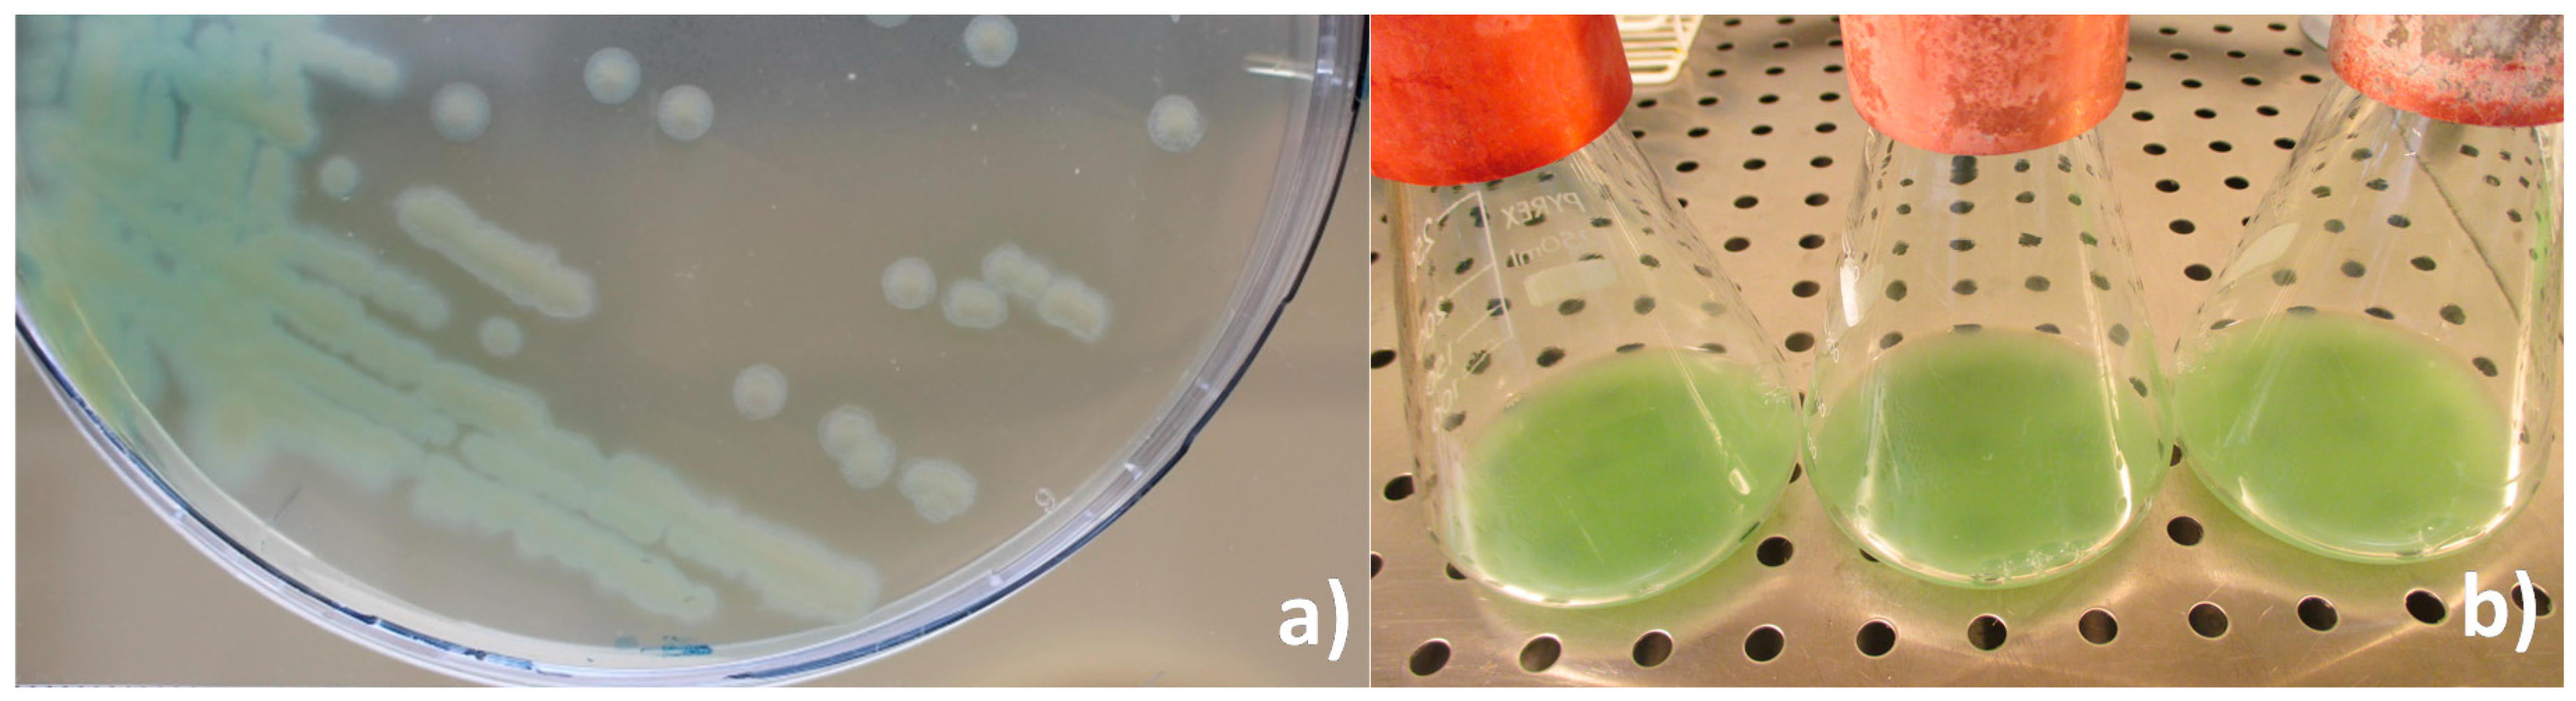

Cannibalism as a Possible Entry Route for Opportunistic Pathogenic Bacteria to Insect Hosts, Exemplified by Pseudomonas aeruginosa, a Pathogen of the Giant Mealworm Zophobas morio
Abstract
1. Introduction
2. Materials and Methods
2.1. P. aeruginosa (Isolation, Identification and Preservation)
2.2. Zophobas morio
2.3. Infection Experiments
2.4. Statistical Analysis of Bioassays
3. Results
3.1. Observations on Disease Symptoms in Z. morio Larvae
3.2. Characterization of P. aeruginosa
3.3. Infection Experiments
4. Discussion and Conclusions
5. Conclusions
Author Contributions
Funding
Acknowledgments
Conflicts of Interest
Appendix A. FASTA Sequence of P. aeruginosa Isolate from Z. morio
References
- Boller, E. Behavioral aspects of mass-rearing of insects. Entomophaga 1972, 17, 9–25. [Google Scholar] [CrossRef]
- Fuxa, J.R.; Sun, J.Z.; Weidner, E.H.; LaMotte, L.R. Stressors and rearing diseases of Trichoplusia ni: Evidence of vertical transmission of NPV and CPV. J. Invertebr. Pathol. 1999, 74, 149–155. [Google Scholar] [CrossRef] [PubMed]
- Steinhaus, E.A. Crowding as a possible stress factor in insect disease. Ecology 1958, 39, 503–514. [Google Scholar] [CrossRef]
- Tanada, Y.; Kaya, H. Insect Pathology, 1st ed.; Academic Press: San Diego, CA, USA, 1993; pp. 147–170. ISBN 0-12-683255-2. [Google Scholar]
- Bucher, G.E. Chapter 4: Non sporulating bacterial pathogens. In Insect Pathology, an Advanced Treatise, 1st ed.; Steinhaus, E., Ed.; Academic Press: New York, NY, USA, 1963; Volume 2, pp. 117–149. [Google Scholar]
- Hendrickson, E.L.; Plotnikova, J.; Mahajan-Miklos, S.; Rahme, L.G.; Ausubel, F.M. Differential roles of the Pseudomonas aeruginosa PA14 rpoN gene in pathogenicity in plants, nematodes, insects, and mice. J. Bacteriol. 2001, 183, 7126–7134. [Google Scholar] [CrossRef] [PubMed]
- Jurat-Fuentes, J.L.; Jackson, T.A. Chapter 8: Bacterial entomopathogens. In Insect Pathology, 2nd ed.; Vega, F.E., Kaya, H.K., Eds.; Academic Press: London, UK, 2012; pp. 265–350. [Google Scholar]
- Lyczak, J.B.; Cannon, C.L.; Pier, G.B. Establishment of Pseudomonas aeruginosa infection: Lessons from a versatile opportunist. Microb Infect. 2000, 2, 1051–1060. [Google Scholar] [CrossRef]
- Hall-Stoodley, L.; Costerton, J.W.; Stoodley, P. Bacterial biofilms: From the Natural environment to infectious diseases. Nat. Rev. Microbiol. 2004, 2, 95. [Google Scholar] [CrossRef] [PubMed]
- Sikorowski, P.P.; Lawrence, A.M. Microbial contamination and insect rearing. Am. Entomol. 1994, 40, 240–253. [Google Scholar] [CrossRef]
- Azambuja, P.; García, E.S.; Ratcliffe, N.A. Gut microbiota and parasite transmission by insect vectors. Trends Parasitol. 2005, 21, 568–572. [Google Scholar] [CrossRef] [PubMed]
- Fuxa, J.R.; Ayyappath, R.; Goyer, R.A. Pathogens and Microbial Control of North American Forest Insect Pests; Forest Health Technology Enterprise Team, USDA Forest Service: Washington, DC, USA, 1998; Volume 97.
- Moore, G.E. Isolating entomogenous fungi and bacteria, and tests of fungal isolates against the Southern pine beetle. J. Econ. Entomol. 1970, 63, 1702–1704. [Google Scholar] [CrossRef]
- Sri-Arunotai, S.; Sikorowski, P.P.; Neel, W.W. Study of the pathogens of the pecan weevil larvae. Environ. Entomol. 1975, 4, 790–792. [Google Scholar] [CrossRef]
- Grimont, F.; Grimont, P.A.D. The Genus Serratia. In The Prokaryotes; Dworkin, M., Falkow, S., Rosenberg, E., Schleifer, K.H., Stackebrandt, E., Eds.; Springer: New York, NY, USA, 2006; pp. 219–244. ISBN 978-0-387-25496-8. [Google Scholar]
- Prinsloo, H.E. The phospholipase and gelatinase activity of gram-negative bacteria isolated from diseased insects, and typing of strains of Serratia marcescens. J. Invertebr. Pathol. 1967, 9, 420–427. [Google Scholar] [CrossRef]
- Scrascia, M.; Pazzani, C.; Valentini, V.; Oliva, M.; Russo, V.; D’Addabbo, P.; Porcelli, F. Identification of pigmented Serratia marcescens symbiotically associated with Rhynchophorus ferrugineus Olivier (Coleoptera: Curculionidae). Microbiol. Open 2016, 5, 883–890. [Google Scholar] [CrossRef] [PubMed]
- Bidari, F.; Shams-Bakhsh, M.; Mehrabadi, M. Isolation and characterization of a Serratia marcescens with insecticidal activity from Polyphylla olivieri (Col.: Scarabaeidae). J. Appl. Entomol. 2018, 142, 162–172. [Google Scholar] [CrossRef]
- Banerjee, A.; Dangar, T. Pseudomonas aeruginosa, a facultative pathogen of red palm weevil, Rhynchophorus ferrugineus. World J. Microbiol. Biotechnol. 1995, 11, 618–620. [Google Scholar] [CrossRef] [PubMed]
- Bucher, G.E. Pathogens of tobacco and tomato hornworms. J. Invertebr. Pathol. 1967, 9, 82–89. [Google Scholar] [CrossRef]
- Bucher, G.E.; Stephens, J.M. A disease of grasshoppers caused by the bacterium Pseudomonas aeruginosa (Schroeter) Migula. Can. J. Microbiol. 1957, 3, 611–625. [Google Scholar] [CrossRef] [PubMed]
- Andrejko, M.; Zdybicka-Barabas, A.; Cytryńska, M. Diverse effects of Galleria mellonella infection with entomopathogenic and clinical strains of Pseudomonas aeruginosa. J. Invertebr. Pathol. 2014, 115, 14–25. [Google Scholar] [CrossRef] [PubMed]
- Lysenko, O. Non-sporeforming bacteria pathogenic to insects: Incidence and mechanisms. Annu. Rev. Microbiol. 1985, 39, 673–695. [Google Scholar] [CrossRef] [PubMed]
- Liu, H.; Lu, B.; Tang, J.; Wang, C.; Li, H.; Yan, Y.; Zhan, L. The separation and identification and drug resistance analysis of the Pseudomonas Aeruginosa of Zophobas Morio. China Anim. Health 2012, 10, 012. [Google Scholar]
- Van Broekhoven, S.; Oonincx, D.G.A.B.; van Huis, A.; van Loon, J.J.A. Growth performance and feed conversion efficiency of three edible mealworm species (Coleoptera: Tenebrionidae) on diets composed of organic by-products. J. Insect Physiol. 2015, 73, 1–10. [Google Scholar] [CrossRef] [PubMed]
- Sánchez-Muros, M.J.; Barroso, F.G.; Manzano-Agugliaro, F. Insect meal as renewable source of food for animal feeding: A review. J. Clean. Prod. 2014, 65, 16–27. [Google Scholar] [CrossRef]
- National Center for Biotechnology Information (NCBI). Available online: https://www.ncbi.nlm.nih.gov/ (accessed on 17 April 2018).
- Budzikiewicz, H. Siderophores of the Pseudomonadaceae sensu stricto (Fluorescent and Non-Fluorescent Pseudomonas spp.). Fortschr. Chem. Org. Naturst. 2004, 87, 81–237. [Google Scholar] [PubMed]
- Meyer, J.M.; Neely, A.; Stintzi, A.; Georges, C.; Holder, I.A. Pyoverdin is essential for virulence of Pseudomonas aeruginosa. Infect. Immun. 1996, 64, 518–523. [Google Scholar] [PubMed]
- Lau, G.W.; Hassett, D.J.; Ran, H.; Kong, F. The role of pyocyanin in Pseudomonas aeruginosa infection. Trends Mol. Med. 2004, 10, 599–606. [Google Scholar] [CrossRef] [PubMed]
- Jander, G.; Rahme, L.G.; Ausubel, F.M. Positive correlation between virulence of Pseudomonas aeruginosa mutants in mice and insects. J. Bacteriol. 2000, 182, 3843–3845. [Google Scholar] [CrossRef] [PubMed]
- Chieda, Y.; Iiyama, K.; Yasunaga-Aoki, C.; Lee, J.M.; Kusakabe, T.; Shimizu, S. Pathogenicity of gacA mutant of Pseudomonas aeruginosa PA01 in the silkworm, Bombyx mori. FEMS Microbiol. Lett. 2005, 244, 181–186. [Google Scholar] [CrossRef] [PubMed]
- Ashrafi, S.H.; Zuberi, R.I.; Hafiz, S. Occurrence of Pseudomonas aeruginosa (Schroeter) Migula as a pathogenic bacterium of the desert locust, Schistocerca gregaria (Forskål). J. Invertebr. Pathol. 1965, 7, 189–191. [Google Scholar] [CrossRef]
- Pimenta, A.L.; Di Martino, P.; Blight, M.A. Positive correlation between in vivo and in vitro assays for the evaluation of Pseudomonas virulence. Res. Microbiol. 2006, 157, 885–890. [Google Scholar] [CrossRef] [PubMed]
- Lau, G.W.; Britigan, B.E.; Hassett, D.J. Pseudomonas aeruginosa OxyR is required for full virulence in rodent and insect models of infection and for resistance to human neutrophils. Infect. Immun. 2005, 73, 2550–2553. [Google Scholar] [CrossRef] [PubMed]
- Sadeh, A.; Northfield, T.D.; Rosenheim, J.A. The epidemiology and evolution of parasite transmission through cannibalism. Ecology 2016, 97, 2003–2011. [Google Scholar] [CrossRef] [PubMed]
- Williams, T. Natural invertebrate hosts to iridoviruses (Iridoviridae). Neotrop. Entomol. 2008, 37, 615–632. [Google Scholar] [CrossRef] [PubMed]
- Richardson, M.L.; Mitchell, R.F.; Reagel, P.F.; Hanks, L.M. Causes and consequences of cannibalism in noncarnivorous insects. Annu. Rev. Entomol. 2010, 55, 39–53. [Google Scholar] [CrossRef] [PubMed]
- Tschinkel, W.R.; Willaon, C.D. Inhibition of pupation due to crowding in some tenebrionid beetles. J. Exp. Zool. 1971, 176, 137–145. [Google Scholar] [CrossRef] [PubMed]
- Tschinkel, W.R. Larval dispersal and cannibalism in a natural population of Zophobas atratus (Coleoptera: Tenebrionidae). Anim. Behav. 1981, 29, 990–996. [Google Scholar] [CrossRef]
- Adamo, S.A. Estimating disease resistance in insects: Phenoloxidase and lysozyme-like activity and disease resistance in the cricket Gryllus texensis. J. Insect Physiol. 2004, 50, 209–216. [Google Scholar] [CrossRef] [PubMed]
- Piesk, M.; Karl, I.; Franke, K.; Fischer, K. High larval density does not induce a prophylactic immune response in a butterfly. Ecol. Entomol. 2013, 38, 346–354. [Google Scholar] [CrossRef]
- Jakubowska, A.K.; Jakubowska, A.K.; D’Angiolo, M.; González-Martínez, R.M.; Millán-Leiva, A.; Carballo, A.; Murillo, R.; Caballero, P.; Herrero, S. Simultaneous occurrence of covert infections with small RNA viruses in the lepidopteran Spodoptera exigua. J. Invertebr. Pathol. 2014, 121, 56–63. [Google Scholar] [CrossRef] [PubMed]
- Jakubowska, A.K.; Murillo, R.; Carballo, A.; Williams, T.; van Lent, J.W.M.; Caballero, P.; Herrero, S. Iflavirus increases its infectivity and physical stability in association with baculovirus. PeerJ 2016, 4, e1687. [Google Scholar] [CrossRef] [PubMed]
- Kemp, E.M.; Woodward, D.T.; Cory, J.S. Detection of single and mixed covert baculovirus infections in eastern spruce budworm, Choristoneura fumiferana populations. J. Invertebr. Pathol. 2011, 107, 202–205. [Google Scholar] [CrossRef] [PubMed]
- Thomas, M.B.; Watson, E.L.; Valverde-Garcia, P. Mixed infections and insect–pathogen interactions. Ecol. Lett. 2003, 6, 183–188. [Google Scholar] [CrossRef]
- Calleri, D.V.; McGrail, R.E.; Rosengaus, R.B.; Vargo, E.L.; Traniello, J.F.A. Inbreeding and disease resistance in a social insect: Effects of heterozygosity on immunocompetence in the termite Zootermopsis angusticollis. Proc. R. Soc. Lon. B 2006, 273, 2633–2640. [Google Scholar] [CrossRef] [PubMed]
- William, O.H.H.; Boomsma, J.J. Genetic Diversity and Disease Resistance in Leaf-Cutting Ant Societies. Evolution 2004, 58, 1251–1260. [Google Scholar]
- Miller, C.V.L.; Cotter, S.C.; Ardia, D. Resistance and tolerance: The role of nutrients on pathogen dynamics and infection outcomes in an insect host. J. Anim. Ecol. 2018, 87, 500–510. [Google Scholar] [CrossRef] [PubMed]
- Krams, I.; Kecko, S.; Kangassalo, K.; Moore, F.R.; Jankevics, E.; Inashkina, I.; Krama, T.; Lietuvietis, V.; Meija, L.; Rantala, M.J. Effects of food quality on trade-offs among growth, immunity and survival in the greater wax moth Galleria mellonella. Insect Sci. 2015, 22, 431–439. [Google Scholar] [CrossRef] [PubMed]
- Krieg, A. Chapter 11: Diseases caused by bacteria and other procaryotes. In Epizootiology of Insect Diseases; Fuxa, J.R., Tanada, Y., Eds.; John Wiley & Sons: Hoboken, NJ, USA, 1987; pp. 323–356. [Google Scholar]
- Stephens, J.M. Chapter 9: Immunity in insects. In Insect Pathology, An Advanced Treatise, 1st ed.; Steinhaus, E., Ed.; Academic Press: New York, NY, USA, 1963; Volume 1, pp. 273–298. ISBN 9-78-032314352-3. [Google Scholar]
- Greany, P.D.; Allen, G.E.; Webb, J.C.; Sharp, J.L.; Chambers, D.L. Stress-induced septicemia as an impediment to laboratory rearing of the fruit fly parasitoid Biosteres (opius) longicaudatus (Hymenoptera: Braconidae) and the Caribbean fruit fly Anastrepha suspensa (Diptera: Tephritidae). J. Invertebr. Pathol. 1977, 29, 153–161. [Google Scholar] [CrossRef]

| Possible Entry Route/Transmission Route | ||
|---|---|---|
| Experiment | Per os | Cuticular |
| Force-feeding | x | |
| Group exposure (feed) | x | x |
| Subdermal injection | x | |
| Purposeful wounding | x | x |
| Microorganism/Reaction | ONPG | ADH | LDC | CIT | H2S | URE | TDA | IND | VP | GEL | GLU | MAN | INO | SOR | RHA | SAC | MEL | AMY | ARA | OX | NO2 |
|---|---|---|---|---|---|---|---|---|---|---|---|---|---|---|---|---|---|---|---|---|---|
| Isolate from Z. morio | X | X | X | X | X | X | X | ||||||||||||||
| P. aeruginosa | X | X | X | X | X | X | X | ||||||||||||||
| P. fluorescens/putida | X | X | X | X | X | X | X | X |
| Order | Insect Species | Instar | Force-Feeding | Diet Incorporation | Sub Dermal Injection | Other Method | Reference | ||||||||
|---|---|---|---|---|---|---|---|---|---|---|---|---|---|---|---|
| Entry Route | Per os | Per os | Cuticular | Cuticular | |||||||||||
| Dose (UFC/ind.) | Mort (%) | DDpi * | Dose (UFC/ind.) | Mort (%) | DDpi * | Dose (UFC/ind.) | Mort (%) | DDpi * | Dose (UFC/ind.) | Mort (%) | DDpi * | ||||
| Lepidoptera | Galleria mellonella (1) | L5 | 1 | 50 | 2+ | [6,31] | |||||||||
| Bombyx mori (2) (3) | L5 | 3.57 × 102 | 60 | 2 | [32] | ||||||||||
| L5 | 3.57 × 104 | 100 | 2 | ||||||||||||
| Orthoptera | Camulla pellucida & Melanoplus bivitattus (4) | - | 8 × 103–2.9 × 103 | 50 | 7–21 | 10–20 | 50 | 2–3 | [21] | ||||||
| Schistocerca gregaria (5) | - | 1.8 × 104–2.4 × 104 | 50 | 2 | 6 × 104 | 100 | 1 | 5.3 × 104 (°) | 100 | 1 | [33] | ||||
| 5.3 × 104 | 100 | 2 | |||||||||||||
| Diptera | Drosophila melanogaster (6) | Adult | - | 50 | 1+ | [34] | |||||||||
| D. melanogaster (2) (7) | Adult | - | 100 | 1+ | [35] | ||||||||||
| Coleoptera | Rynchophorus ferrugineus (8) | L1 | 1 × 105 | 50 | 9 × 102 | 50 | 6 ± 3 | 1 × 105 | 50 | 8 ± 3 | [19] | ||||
| L2 | 1 × 105 | 50 | 1 × 103 | 50 | 6 ± 3 | 1 × 105 | 50 | 8 ± 3 | |||||||
| PP | 4 × 105 | 50 | 2 × 103 | 50 | 6 ± 3 | 2 × 105 | 50 | 8 ± 3 | |||||||
| Z. morio (9) | L | 1.1 × 107 | 56 | 1–2 | 5.4 × 106 | 98 | 1–2 | 2.2 × 107 (^) | 32 | 11–12 | This work | ||||
| L | 5.4 × 106 | 30 | 1–2 | 5.4 × 105 | 41 | 4–5 | 3.6 × 107 (^^) | 56.6 | 15 | ||||||
© 2018 by the authors. Licensee MDPI, Basel, Switzerland. This article is an open access article distributed under the terms and conditions of the Creative Commons Attribution (CC BY) license (http://creativecommons.org/licenses/by/4.0/).
Share and Cite
Maciel-Vergara, G.; Jensen, A.B.; Eilenberg, J. Cannibalism as a Possible Entry Route for Opportunistic Pathogenic Bacteria to Insect Hosts, Exemplified by Pseudomonas aeruginosa, a Pathogen of the Giant Mealworm Zophobas morio. Insects 2018, 9, 88. https://doi.org/10.3390/insects9030088
Maciel-Vergara G, Jensen AB, Eilenberg J. Cannibalism as a Possible Entry Route for Opportunistic Pathogenic Bacteria to Insect Hosts, Exemplified by Pseudomonas aeruginosa, a Pathogen of the Giant Mealworm Zophobas morio. Insects. 2018; 9(3):88. https://doi.org/10.3390/insects9030088
Chicago/Turabian StyleMaciel-Vergara, Gabriela, Annette Bruun Jensen, and Jørgen Eilenberg. 2018. "Cannibalism as a Possible Entry Route for Opportunistic Pathogenic Bacteria to Insect Hosts, Exemplified by Pseudomonas aeruginosa, a Pathogen of the Giant Mealworm Zophobas morio" Insects 9, no. 3: 88. https://doi.org/10.3390/insects9030088
APA StyleMaciel-Vergara, G., Jensen, A. B., & Eilenberg, J. (2018). Cannibalism as a Possible Entry Route for Opportunistic Pathogenic Bacteria to Insect Hosts, Exemplified by Pseudomonas aeruginosa, a Pathogen of the Giant Mealworm Zophobas morio. Insects, 9(3), 88. https://doi.org/10.3390/insects9030088

